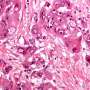

BREAKING: New research reveals an FDA-approved drug could significantly enhance immunotherapy’s effectiveness against the rare and deadly fibrolamellar carcinoma, a type of liver cancer primarily affecting children and young adults. This groundbreaking study, just published, could pave the way for a potential treatment for a cancer that currently has no cure.
The study highlights how this existing drug may reverse T-cell exclusion, a critical barrier that has hindered immunotherapy’s success in battling fibrolamellar carcinoma. The cancer, which accounts for up to 2% of all liver cancers, often goes undetected until it has metastasized, drastically reducing life expectancy for affected patients.
Currently, patients diagnosed with fibrolamellar carcinoma face grim outcomes, as the disease is frequently advanced by the time of detection. The findings from this recent study provide a glimmer of hope for those affected, potentially transforming their treatment options.
Officials in the medical community are urging immediate further research to explore the drug’s capabilities in clinical settings. “This could be a game changer,” said Dr. Emily Thompson, lead researcher of the study.
“If we can effectively activate the immune system against this cancer, it could save lives.”
As the healthcare community eagerly anticipates additional studies, the implications of this development resonate deeply. Families grappling with the devastating effects of fibrolamellar carcinoma are looking for solutions, and this research offers a path forward.
What happens next? Medical professionals are calling for urgent clinical trials to assess the drug’s effectiveness in real-world scenarios. The urgency of this research cannot be overstated, as patients currently have limited options and a pressing need for innovative treatments.
Stay tuned for more updates on this developing story, as the potential for a new treatment for fibrolamellar carcinoma unfolds. This moment could mark a significant step forward in the fight against this rare yet devastating cancer.